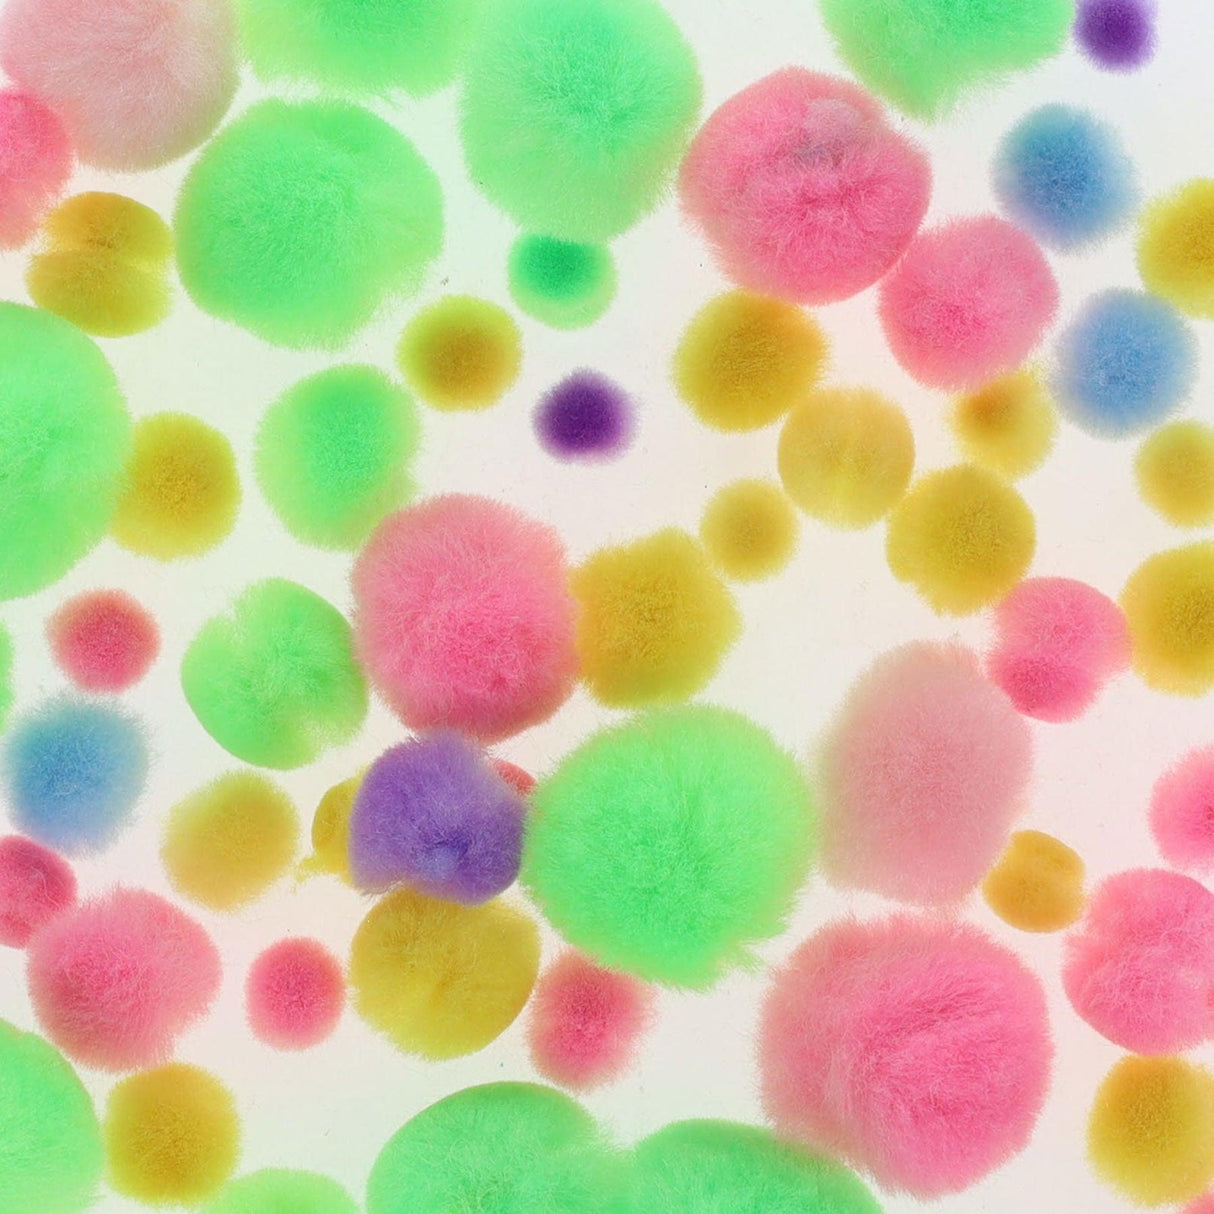
Crafty Bitz - Pom Poms - Pastel - Pack of 70 by Crafty Bitz on Schoolbooks.ie

Crafty Bitz - Pom Poms - Pastel - Pack of 70
€1.50
Unit price
/
Unavailable
Crafty Bitz - Pom Poms - Pastel - Pack of 70 is available to BACKORDER. If you order this item now, your full order will only ship when this item is received into stock.
Delivery and Shipping
Delivery and Shipping
All orders shipped from our warehouse in Ireland
All orders shipped from our warehouse in Ireland
All orders are despatched from our warehouse in Oranmore, Co. Galway, Ireland
No additional taxes will apply
No additional taxes will apply
The prices quoted on our website are inclusive of tax (VAT)
Crafty Bitz - Pom Poms - Pastel - Pack of 70
- Fluffy pom-poms are an essential addition to any craft kit
- Whether you're decorating, gluing, or simply having fun, our pom-poms are perfect for any project.
-
SubjectArt
-
ISBN-13
-
Barcode
-
Weight
-
Vendor Reference